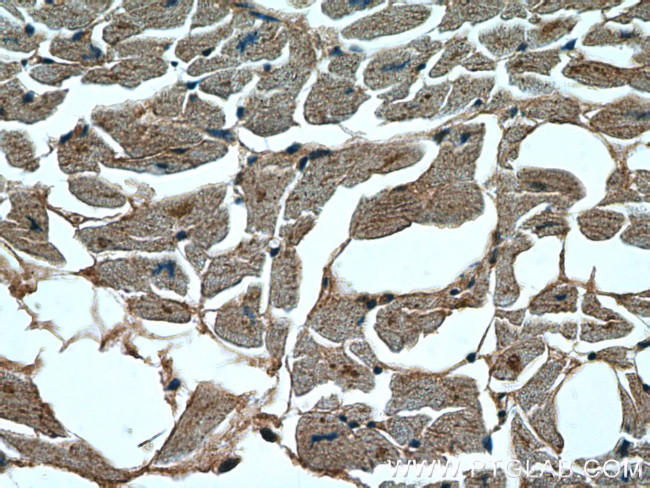
STK38L Antibody in Immunohistochemistry (Paraffin) (IHC (P))

Search
Proteintech
STK38L Polyclonal Antibody
{{$productOrderCtrl.translations['antibody.pdp.commerceCard.promotion.promotions']}}
{{$productOrderCtrl.translations['antibody.pdp.commerceCard.promotion.viewpromo']}}
{{$productOrderCtrl.translations['antibody.pdp.commerceCard.promotion.promocode']}}: {{promo.promoCode}} {{promo.promoTitle}} {{promo.promoDescription}}. {{$productOrderCtrl.translations['antibody.pdp.commerceCard.promotion.learnmore']}}
产品信息
12697-1-AP
种属反应
宿主/亚型
分类
类型
抗原
偶联物
形式
浓度
规格
纯化类型
保存液
内含物
保存条件
运输条件
产品详细信息
This antibody is specific to STK38L.
Immunogen sequence: FESLKVIGR GAFGEVRLVQ KKDTGHIYAM KILRKSDMLE KEQVAHIRAE RDILVEADGA WVVKMFYSFQ DKRNLYLIME FLPGGDMMTL LMKKDTLTEE ETQFYISETV LAIDAIHQLG FIHRDIKPDN LLLDAKGHVK LSDFGLCTGL KKAHRTEFYR NLTHNPPSDF SFQNMNSKRK AETWKKNRRQ LAYSTVGTPD YIAPEVFMQT GYNKLCDWWS LGVIMYEMLI GYPPFCSETP QETYRKVMNW KETLVFPPEV PISEKAKDLI LRFCIDSENR IGNSGVEE (90-376 aa encoded by BC028603 )
靶标信息
STK38L (also known as NDR2) or Nuclear Dbf2-related protein is a serine/threonine kinase in the subgroup of the AGC kinase family. STK38L act as novel pro-apoptotic kinase that is activated by RASSF1A/MST1 in response to Fas receptor stimulation and promotes apoptosis. STK38L is mainly involved in the regulation of structural processes in differentiating and mature neuronal cells and it is highly expressed with highest levels observed in the thymus. STK38L contains 12 protein kinase catalytic subdomains and a potential bipartite nuclear localization signal.
仅用于科研。不用于诊断过程。未经明确授权不得转售。
篇参考文献 (0)
生物信息学
蛋白别名: NDR2 protein kinase; nuclear Dbf2-related 2; Nuclear Dbf2-related kinase 2; serine/threonine kinase 38-like; Serine/threonine-protein kinase 38-like; stk38l; unnamed protein product
基因别名: 4930473A22Rik; B230328I19; KIAA0965; NDR2; Ndr54; RGD1564793; STK38L
UniProt ID: (Human) Q9Y2H1, (Mouse) Q7TSE6
Entrez Gene ID: (Human) 23012, (Mouse) 232533, (Rat) 691337